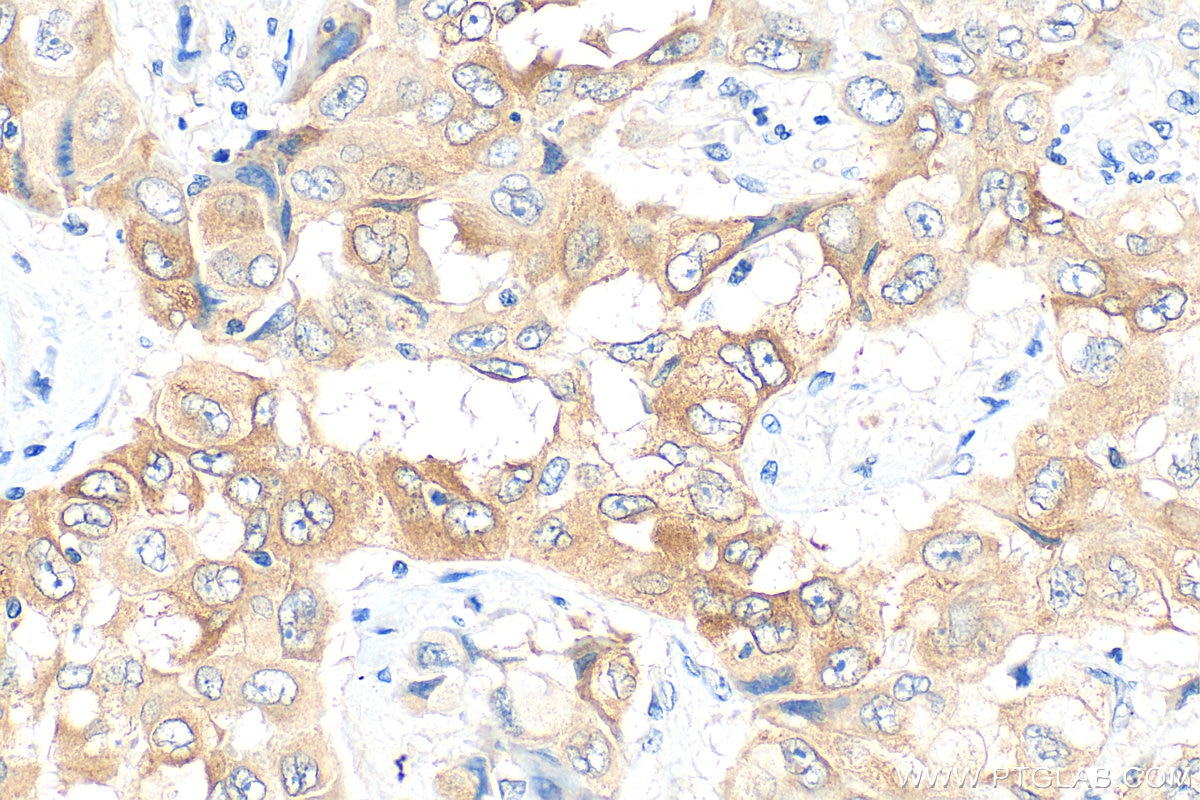
Immunohistochemistry (IHC) staining of human lung cancer tissue using LPCAT1 Monoclonal antibody (66044-1-Ig)

Tested Applications
| Positive WB detected in | LNCaP cells, MCF-7 cells, PC-12 cells, ROS1728 cells, HeLa cells, HEK-293 cells, HepG2 cells, Jurkat cellls, K-562 cells, HSC-T6 cells, NIH/3T3 cells, 4T1 cells |
| Positive IHC detected in | human lung cancer tissue, human liver cancer tissue, mouse lung tissue Note: suggested antigen retrieval with TE buffer pH 9.0; (*) Alternatively, antigen retrieval may be performed with citrate buffer pH 6.0 |
| Positive IF-P detected in | mouse lung tissue |
| Positive IF/ICC detected in | HeLa cells |
Recommended dilution
| Application | Dilution |
|---|---|
| Western Blot (WB) | WB : 1:5000-1:50000 |
| Immunohistochemistry (IHC) | IHC : 1:50-1:500 |
| Immunofluorescence (IF)-P | IF-P : 1:200-1:800 |
| Immunofluorescence (IF)/ICC | IF/ICC : 1:400-1:1600 |
| It is recommended that this reagent should be titrated in each testing system to obtain optimal results. | |
| Sample-dependent, Check data in validation data gallery. | |
Published Applications
| KD/KO | See 4 publications below |
| WB | See 9 publications below |
| IHC | See 5 publications below |
| IF | See 2 publications below |
Product Information
66044-1-Ig targets LPCAT1 in WB, IHC, IF/ICC, IF-P, ELISA applications and shows reactivity with human, mouse, rat samples.
| Tested Reactivity | human, mouse, rat |
| Cited Reactivity | human, mouse, rat |
| Host / Isotype | Mouse / IgG2b |
| Class | Monoclonal |
| Type | Antibody |
| Immunogen |
CatNo: Ag9060 Product name: Recombinant human LPCAT1 protein Source: e coli.-derived, PET28a Tag: 6*His Domain: 51-395 aa of BC020166 Sequence: IKRRAQSNGKWPQIMIFPEGTCTNRTCLITFKPGAFIPGAPVQPVVLRYPNKLDTITWTWQGPGALEILWLTLCQFHNQVEIEFLPVYSPSEEEKRNPALYASNVRRVMAEALGVSVTDYTFEDCQLALAEGQLRLPADTCLLEFARLVRGLGLKPEKLEKDLDRYSERARMKGGEKIGIAEFAASLEVPVSDLLEDMFSLFDESGSGEVDLRECVVALSVVCRPARTLDTIQLAFKMYGAQEDGSVGEGDLSCILKTALGVAELTVTDLFRAIDQEEKGKITFADFHRFAEMYPAFAEEYLYPDQTHFESCAETSPAPIPNGFCADFSPENSDAGRKPVRKKLD Predict reactive species |
| Full Name | lysophosphatidylcholine acyltransferase 1 |
| Calculated Molecular Weight | 534 aa, 59 kDa |
| Observed Molecular Weight | 55 kDa |
| GenBank Accession Number | BC020166 |
| Gene Symbol | LPCAT1 |
| Gene ID (NCBI) | 79888 |
| RRID | AB_11045658 |
| Conjugate | Unconjugated |
| Form | Liquid |
| Purification Method | Protein A purification |
| UNIPROT ID | Q8NF37 |
| Storage Buffer | PBS with 0.02% sodium azide and 50% glycerol, pH 7.3. |
| Storage Conditions | Store at -20°C. Stable for one year after shipment. Aliquoting is unnecessary for -20oC storage. 20ul sizes contain 0.1% BSA. |
Background Information
LPCAT1, also named as AYTL2, PFAAP3 and LysoPAFAT, belongs to the 1-acyl-sn-glycerol-3-phosphate acyltransferase family. It is a key enzyme for remodeling phospholipids, including phosphatidylcholine. The expression level of LPCAT1 is able to differentiate prostate cancer from noncancerous prostatic changes, and correlates to the tumor grade of prostate cancer. LPCAT1 possesses both acyltransferase and acetyltransferase activities. It mediates the conversion of 1-acyl-sn-glycero-3-phosphocholine (LPC) into phosphatidylcholine (PC).
Protocols
| Product Specific Protocols | |
|---|---|
| IF protocol for LPCAT1 antibody 66044-1-Ig | Download protocol |
| IHC protocol for LPCAT1 antibody 66044-1-Ig | Download protocol |
| WB protocol for LPCAT1 antibody 66044-1-Ig | Download protocol |
| Standard Protocols | |
|---|---|
| Click here to view our Standard Protocols |
Publications
| Species | Application | Title |
|---|---|---|
Cell Metab Oncogene Amplification in Growth Factor Signaling Pathways Renders Cancers Dependent on Membrane Lipid Remodeling.
| ||
Biochim Biophys Acta Mol Basis Dis Stearoyl-CoA desaturase 1 deficiency exacerbates palmitate-induced lipotoxicity by the formation of small lipid droplets in pancreatic β-cells | ||
Front Oncol Gut Microbiota Dysbiosis Accelerates Prostate Cancer Progression Through Increased LPCAT1 Expression and Enhanced DNA Repair Pathways. | ||
Sci Rep No evidence for carcinogenicity of titanium dioxide nanoparticles in 26-week inhalation study in rasH2 mouse model | ||
Biochem Biophys Res Commun A miR-205-LPCAT1 axis contributes to proliferation and progression in multiple cancers.
| ||
Cell Death Dis LPCAT1 reprogramming cholesterol metabolism promotes the progression of esophageal squamous cell carcinoma.
|